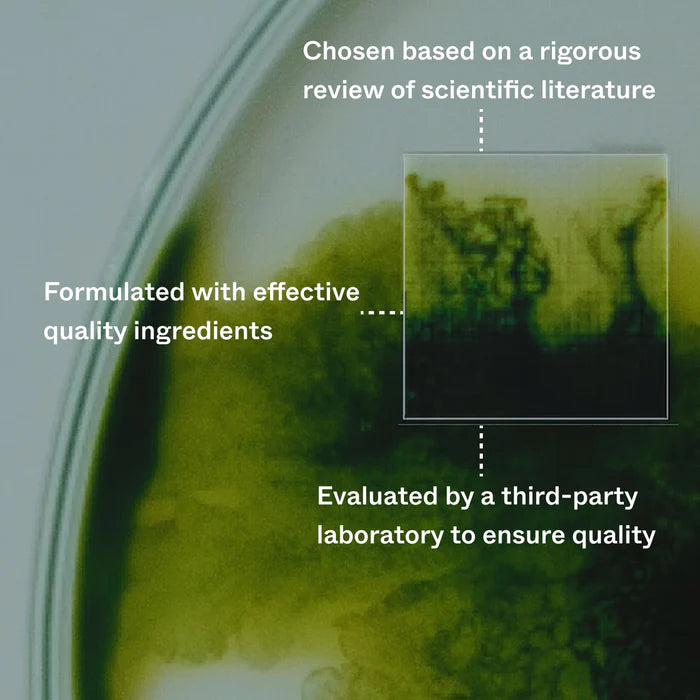

Scandinavian Biolabs
Bio-Pixilin Activation Serum+ Men
- Ordinarie pris
- 429 kr
- Försäljningspris
- 429 kr
- Ordinarie pris
- 479 kr
Det gick inte att ladda hämtningstillgänglighet
Beskrivning
Scandinavian Biolabs Bio-Pilixin Activation Serum+ är ett avancerat och vetenskapligt utvecklat serum som hjälper till att minska håravfall och stimulera ny hårväxt. Med en kraftfull formula, inspirerad av naturens egna mekanismer, arbetar serumet för att ge näring till hårsäckarna och skapa optimala förutsättningar för starkare och fylligare hår.
I hjärtat av formulan finns Capilia Longa, ett växtbaserat extrakt från Curcuma Longa, som i kliniska studier har visat sig kunna minska håravfall med upp till 89 % och öka hårtätheten med 52 %. Tillsammans med niacinamid, som stärker hårstråna genom att stimulera keratinproduktionen och skydda mot oxidativ stress, bidrar serumet till ett friskare och mer motståndskraftigt hår.
Effekten av Bio-Pilixin Activation Serum är kliniskt bevisad. En studie visade att 77 % av användarna upplevde minskat håravfall redan efter 45 dagar, medan 93 % såg en signifikant minskning av håravfall efter 150 dagar. Dessutom rapporterade 73 % en mätbar ökning av hårtätheten.
Serumet är dermatologiskt testat och fritt från läkemedel och hormoner. Formulan är 100 % vegansk och cruelty-free. Bio-Pilixin Activation Serum+ är det perfekta valet för dig som vill ta ett vetenskapligt beprövat och naturligt steg mot ett fylligare och starkare hår.